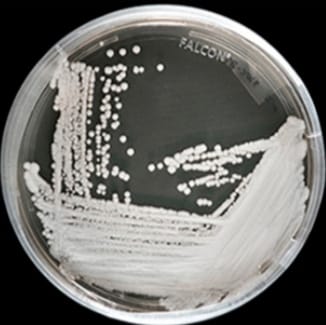
...

Investigación

Fuertes explosiones en aereopuerto de Yemen. Hay varios muertos
Podría ser un atentando
hace 5 añosLeer más
Detectan hongo Candida Auris mortal en pacientes que tuvieron COVID-19
De los 10 pacientes cinco presentaron la infección en el torrente sanguíneo, y cinco en vías urinarias
hace 5 añosLeer más

Asesinan a tiros a Malala Maiwand, periodista y activista en Afganistán y el mundo
Pérdida para el mundo
hace 5 añosLeer más

Se podrá ver la estrella de Belén después de 800 años
Será a partir del próximo 21 de diciembre
hace 5 añosLeer más

Reino Unido aprueba vacuna contra Covid-19
Con información de CNN
hace 5 añosLeer más
Página 8 de 8
Total de elementos: 153